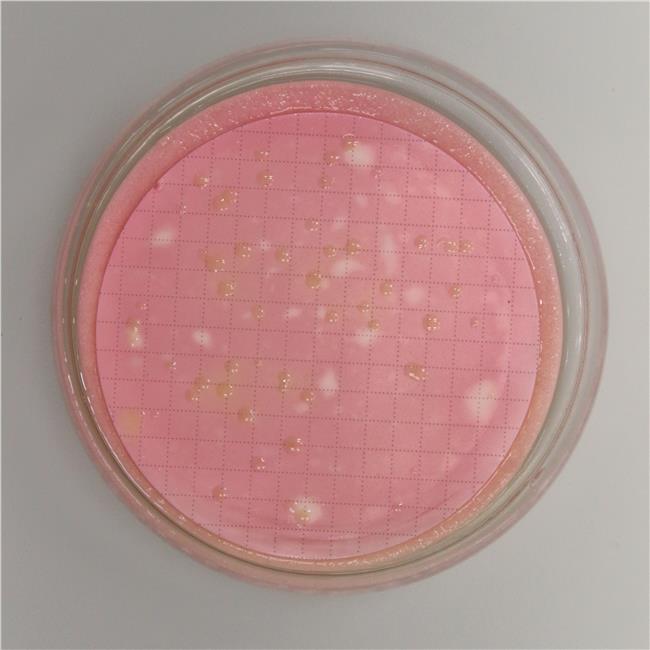

Easy DryTM are absorbent pads saturated with a sterile, dehydrated culture medium. Each pad is pre-plated in a Petri dish and is immediately ready to use after pouring sterile distilled or deionized water on it. Easy DryTM are optimal for the examination of large sample volumes by the membrane filter method.
Easy DryTM Violet Red Bile Glucose (VRBG) is a selective isolation medium used for the detection and enumeration of Enterobacteriaceae and bile-tolerant Gram-negative bacteria in filterable samples, especially water.
VRBG agar (the corresponding agar medium) is described in the following standards:
- ISO 21528 (parts 1 and 2) for examination of food, animal feed, and environmental samples in the area of primary production, food production and food handling;
- Harmonized USP/EP/JP for testing non-sterile pharmaceutical products.
PREPARATION
1.
Cut open a bag and remove the number of Easy Dry plates needed.
2.
Moisten the pad contained
in the Petri dish with 2.2 ml of sterile distilled or deionized water.
3.
Wait 5 minutes before
using.
TEST PROCEDURE
Filter the sample through a filter membrane (0.45 µm pore diameter). Transfer the membrane onto a plate containing a just rehydrated pad. Incubate aerobically at 37 ± 1°C for 22-24 hours.
INTERPRETING RESULTS
Characteristic colonies are pink to red.
Confirm by subculturing to a non-selective agar medium, e.g. nutrient agar plates, looking for oxidase reaction (ref. 88029) and glucose fermentation (ref. 88202). Colonies that are oxidase-negative and glucose-positive are confirmed as Enterobacteriaceae.
APPEARANCE OF THE MEDIUM
Whitish pad. Reddish-purple once rehydrated.
STORAGE
Store at 10-25°C away from light. Do not
use the product beyond its expiry date on the label or if product shows any
evidence of contamination or any sign of deterioration.
SHELF LIFE
2 years.